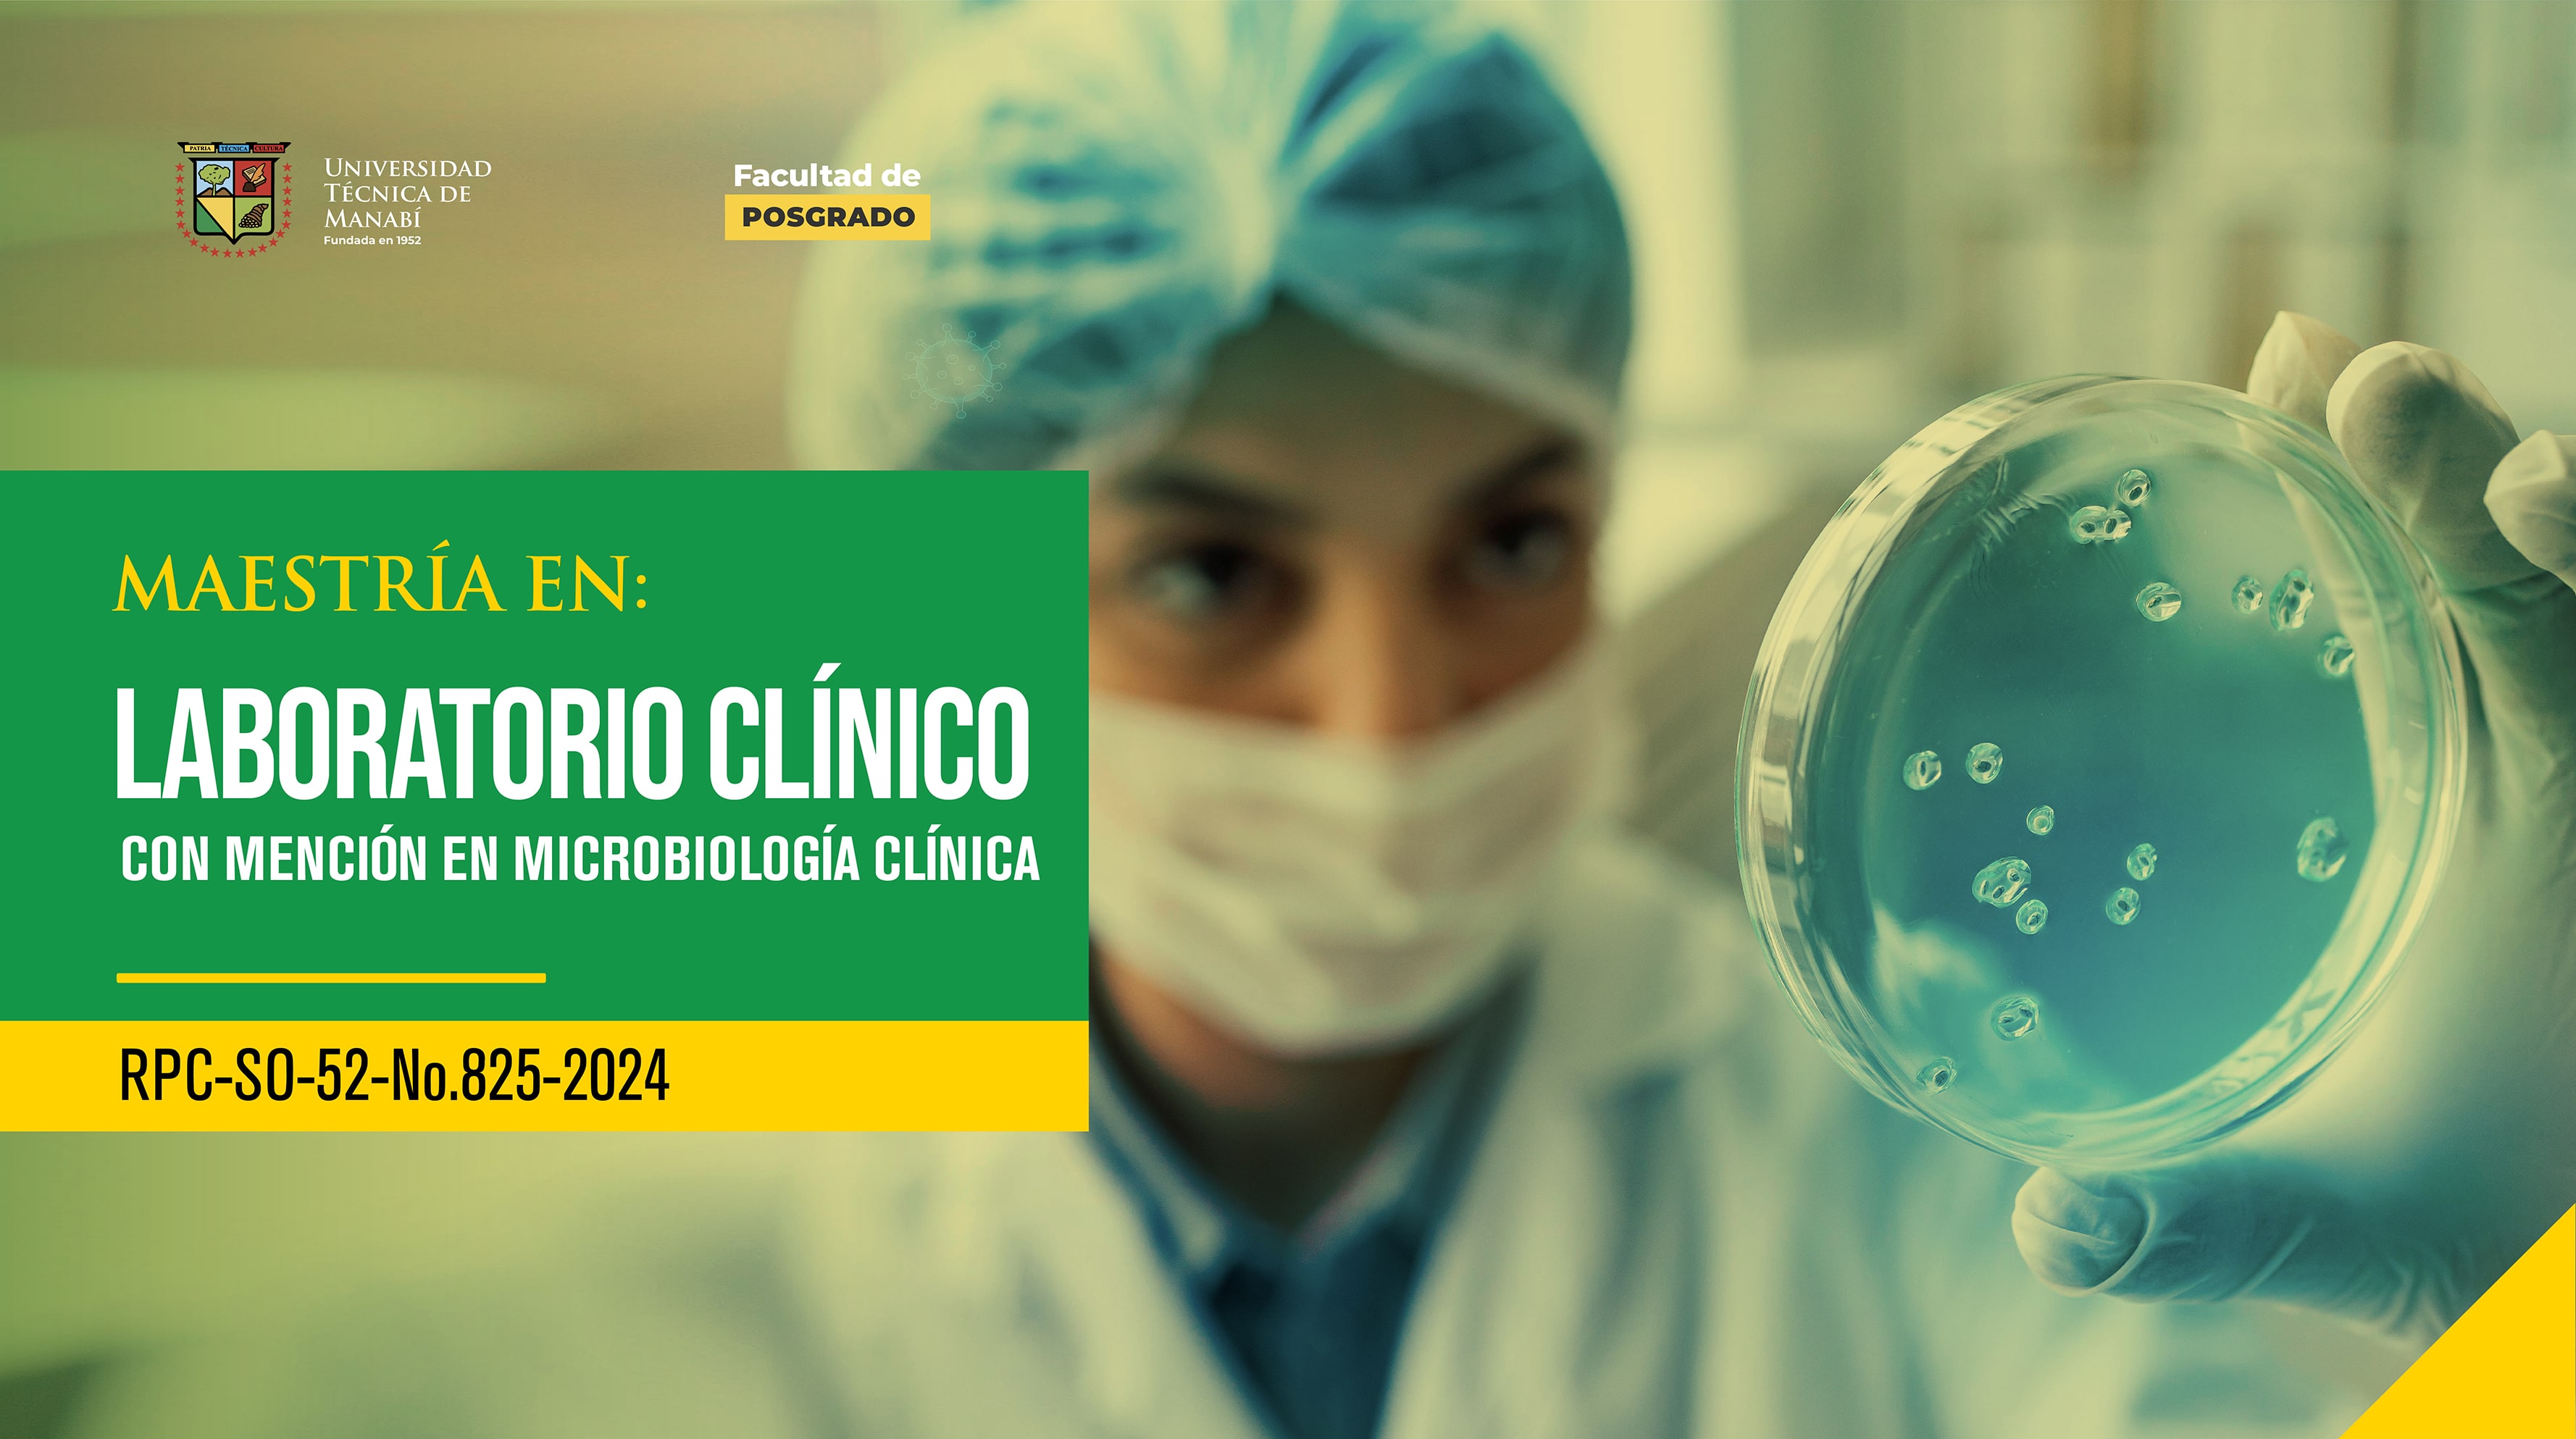
Image

El graduado de la Maestría académica en Laboratorio Clínico con mención en Microbiología Clínica, será capaz de seleccionar y efectuar técnicas avanzadas de diagnóstico por laboratorio, para la identificación de microorganismos patógenos en muestras clínicas; así mismo tendrá la capacidad necesaria para interpretar y analizar resultados microbiológicos con precisión y rigor científico. Demostrar competencia para investigar y desarrollar nuevos métodos y tecnologías en el campo del laboratorio clínico en relación con la microbiología clínica, así como, capacidad para comunicar de manera efectiva los resultados de sus investigaciones tanto a nivel académico como a la comunidad científica. Estos profesionales mostrarán dominio de técnicas moleculares avanzadas en el laboratorio clínico para la detección de microorganismos y resistencia antimicrobiana; además manifestar un conocimiento profundo de las diferentes pruebas diagnósticas microbiológicas y sus aplicaciones clínicas. Este profesional tiene la capacidad para aplicar metodologías de investigación en función del laboratorio clínico y la microbiología clínica, para la generación de nuevo conocimiento científico; así como, destreza en el manejo de equipos y tecnologías de vanguardia, utilizados en laboratorios clínicos. Será capaz de desarrollar investigaciones orientadas al manejo de equipos y tecnologías de vanguardia en función de laboratorios clínicos y en relación a la prevención, diagnóstico y tratamiento de enfermedades infecciosas, incluyendo la implementación de programas de vigilancia epidemiológica para controlar la propagación de las enfermedades infecciosas en comunidades. Podrá colaborar con instituciones de salud y organismos gubernamentales para mejorar la gestión de los laboratorios clínicos y promover la salud pública. Todas sus actividades profesionales demostrarán ética profesional y responsabilidad en la práctica clínica y de investigación, evidenciando respeto a la diversidad cultural y a los derechos humanos en el ejercicio del laboratorio clínico y la microbiología clínica. Además, compromiso con el desarrollo sostenible y la protección del medio ambiente en la realización de sus actividades profesionales.